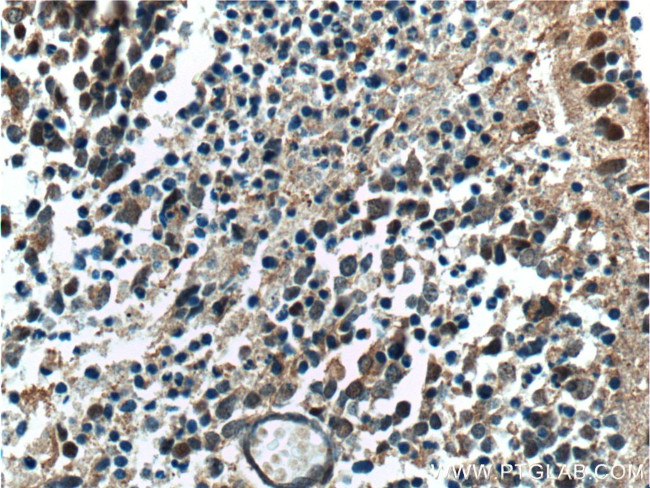
NRL Antibody in Immunohistochemistry (Paraffin) (IHC (P))

Search
Proteintech
NRL Polyclonal Antibody
{{$productOrderCtrl.translations['antibody.pdp.commerceCard.promotion.promotions']}}
{{$productOrderCtrl.translations['antibody.pdp.commerceCard.promotion.viewpromo']}}
{{$productOrderCtrl.translations['antibody.pdp.commerceCard.promotion.promocode']}}: {{promo.promoCode}} {{promo.promoTitle}} {{promo.promoDescription}}. {{$productOrderCtrl.translations['antibody.pdp.commerceCard.promotion.learnmore']}}
产品信息
17388-1-AP
种属反应
宿主/亚型
分类
类型
抗原
偶联物
形式
浓度
规格
纯化类型
保存液
内含物
保存条件
运输条件
产品详细信息
Immunogen sequence: MALPPSPLA MEYVNDFDLM KFEVKREPSE GRPGPPTASL GSTPYSSVPP SPTFSEPGMV GATEGTRPGL EELYWLATLQ QQLGAGEALG LSPEEAMELL QGQGPVPVDG PHGYYPGSPE ETGAQHVQLA ERFSDAALVS MSVRELNRQL RGCGRDEALR LKQRRRTLKN RGYAQACRSK RLQQRRGLEA ERARLAAQLD ALRAEVARLA RERDLYKARC DRLTSSGPGS GDPSHLFL (1-237 aa encoded by BC012395)
靶标信息
Nrl (neural retina leucine zipper) is a member of the Maf family of transcription factors, which characteristically contain a highly conserved basic leucine zipper (bZIP)-DNA binding motif. Both Nrl and c-Maf preferentially bind to T-MARE sites and are implicated in a wide variety of developmental and physiologic roles. The Maf-Nrl subfamily regulates the expression of cell type-specific genes in tissues of the hematopoietic system, cerebellum and developing hindbrain. Maf and Nrl proteins bind an extended AP-1-like sequence and can form heterodimers with Fos and Jun transcription factors. In retinal cells and photoreceptor cells, Nrl promotes the expression of rhodopsin through binding to the Nrl response element present in the rhodopsin promoter. Nrl is expressed throughout the developing central and peripheral nervous system during neuronal differentiation, and its expression is restricted to neocortex, brainstem and retinal neurons during adulthood.
仅用于科研。不用于诊断过程。未经明确授权不得转售。
生物信息学
蛋白别名: Maf-family bZIP transcription factor NRL; Neural retina-specific leucine zipper protein; neural retinal-specific leucine zipper; NRL; The gene is named NRL because it is expressed in neural retina andencodes a putative protein with a leucine zipper. Sequence similarity withv-maf oncogene [AAFVMAF].; unnamed protein product
基因别名: D14H14S46E; D14S46E; NRL; NRL-MAF; RP27
UniProt ID: (Human) P54845, (Mouse) P54846
Entrez Gene ID: (Human) 4901, (Rat) 290221, (Mouse) 18185